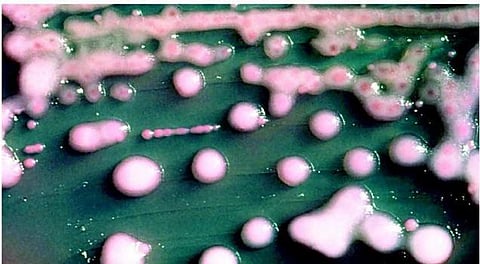
தடுப்பு மருந்துக்குக் கட்டுப்படாத நோய்கள்

அமெரிக்காவில் ஆண்டுதோறும் 23,000 பேர் நோய்த் தொற்றுகளால் மட்டும் உயிரிழக்கின்றனர். நோய்த் தடுப்பு மருந்து மாத்திரைகள் ஏராளமாக தயாரிக்கப்பட்டு வழங்கப்பட்டாலும் அவற்றுக்கும் கட்டுப்படாத நோய்த் தொற்றுகளால் ஆண்டுக்கு 20 லட்சம் பேருக்கு உடல்நலம் கெடுகிறது. இது இப்போது மிகப் பெரிய சுகாதாரப் பிரச்சினையாக உருவெடுத்துவருகிறது. எனவேதான், அமெரிக்காவின் சுகாதார அதிகாரிகள் முதல் முறையாக நோய் எதிர்ப்பு மருந்துகளுக்குக் கட்டுப்படாதவற்றைப் பட்டியலிட்டுள்ளனர்.
"உயிரிழந்தவர் எண்ணிக்கை கடந்த சில ஆண்டுகளைவிடக் குறைவாக இருக்கிறது. காரணம், தடுப்பு மருந்துகளுக்குக் கட்டுப்படாத நோய்த் தொற்று இறந்தவர்களிடத்தில் இருந்தாலும் அதனால்தான் இறந்தார் என்று திட்டவட்டமாகத் தெரியாததால் பலருடைய மரணங்கள் இதில் சேர்க்கப்படவில்லை.
‘நோய் ஏற்படுத்தும் பாக்டீரியாக்களைக் கொல்ல மருந்துகளை நாம் தயாரித்தாலும், அந்த மருந்துகளால் பாக்டீரியாக்களிடமும் மருந்து எதிர்ப்பு சக்தி அதிகரிக்கிறது. பிறகு அது பல மடங்கு வீரியத்துடன் வந்து சமூகத்தைத் தாக்குகிறது. அப்போது சாதாரண நோய்த் தொற்றுக்கே மனிதர்கள் இறக்க நேரிடும்’ என்று விஞ்ஞானிகள் எச்சரித்திருந்தனர். எனவேதான், இப்போதைய உயிரிழப்புகள் கவனமுடன் ஆராயப்படுகின்றன. தோராயமாகக் கணக்கிட்டு இறப்பு எவ்வளவு என்று முன்னர் கூறிவந்தவர்கள் இப்போது துல்லியமாகக் கணக்கிட்டு தெரிவிக்கின்றனர்" என்று டப்ட்ஸ் பல்கலைக்கழக நுண்ணியிரியல் துறைப் பேராசிரியர் டாக்டர் ஸ்டூவர்ட் லெவி தெரிவிக்கிறார். நோய் எதிர்ப்பு மருந்துகளை அளவோடு பயன்படுத்துவதற்கான சங்கத்தின் தலைவராகவும் அவர் செயல்படுகிறார்.
உலகமெங்கும் மருத்துவமனைகளில் ஏற்பட்ட நோய்த் தொற்றுகளால் மட்டும் ஒரு லட்சம் பேர் வரை இறந்திருக்கலாம் என்று 2007-ல் மதிப்பிடப்பட்டது. சிலவகை நோய்த் தடுப்பு மருந்துகளுக்குக் கட்டுப்படாத நோய்க்கிருமிகளால் இந்த மரணங்கள் ஏற்பட்டது. ஆனால் பரவலாகப் பயன்படுத்தப்படும் நோய்த் தடுப்பு மருந்துகள் பல பலனற்றுப் போய்விடவில்லை என்று இந்த ஆய்வு முடிவுக்கு வந்தது. இந்தக் கணக்கெடுப்பில் வேண்டுமென்றே இறப்பைக் குறைத்துக் காட்டியிருப்பதாக டாக்டர் ஸ்டீவன் சாலமன் தெரிவிக்கிறார். "நோய்த் தடுப்பு மருந்துகளுக்குக் கட்டுப்படாமல் இறப்பு ஏற்பட்டது என்று திட்டவட்டமாகத் தெரியவந்த இறப்புகளை மட்டும் கணக்கில் சேர்க்குமாறு கூறப்பட்டது" என்றார்.
அமெரிக்காவில் உள்ள பால், இறைச்சி, முட்டைகளுக்காக வளர்க்கப்படும் கால்நடைகள், கோழி, வாத்து போன்ற பறவைப் பண்ணை களில்தான் 70% நோய்த்தடுப்பு மருந்துகள் பயன்படுத்தப்படுகின்றன. அந்த மருந்துகளினால் ஏற்படும் விளைவுகளைச் சரியாக ஆராய அந்தப் பண்ணைகளிடமிருந்து ஒத்துழைப்பு கிடைப்பதில்லை. நோய்த் தடுப்பு மருந்துகளைக் கால்நடைகளும் உட்கொள்வதால் அவற்றின் இறைச்சியை உண்ணும் மனிதர்களின் உணவிலும் அப்படியே உடலிலும் இவை சேருகின்றன. எனவே நோய்த்தடுப்பு மருந்துகளுக்குக் கட்டுப்படாத பாக்டீரியாக்களைப் பற்றிய ஆராய்ச்சி முக்கியத்துவம் பெறுகிறது. பிராணிகளுக்குப் பண்ணையில் நோய்த்தடுப்பு மருந்து நோய் வராமல் இருப்பதற்காக மட்டுமல்ல, வேகமாக வளர்வதற்காகவும் தரப்படுகிறது.
இப்படி பிராணிகளுக்குத் தரப்படும் நோய் எதிர்ப்பு மருந்துகளில் பெரும்பாலானவை அவற்றுக்குத் தேவையானவையே அல்ல, அத்துடன் பொருத்தமானவையும் அல்ல. மனிதர்களுக்குத் தரப்படும் நோய் எதிர்ப்பு மருந்து ரகங்களிலும் பாதிக்கு மேல் பொருத்தமானவை அல்ல.
பாக்டீரியாக்களில் 17-வகையும் ஒரு பூஞ்சையும்தான் அமெரிக்காவில் பெரும்பாலான மருந்துகளுக்குக் கட்டுப்படாத நோய்க்கிருமி வகை களை உருவாக்குவதாக ஆய்வுகள் தெரிவிக்கின்றன. நாட்டின் வெவ்வேறு மாநிலங்களில் உள்ள 10 பெரிய மருத்துவமனைகளிலிருந்தும் பிற இடங்களிலிருந்தும் தகவல்கள் பெறப்பட்டு ஆராயப்பட்டன. "சி.ஆர்.இ. என்று பெயரிடப்பட்ட ஒருவகை பாக்டீரியா இப்போது அமெரிக்காவில் விற்கப்படும் எல்லாவகை நோய்த் தடுப்பு மருந்துகளுக்கும் கட்டுப்படாததாக இருக்கிறது. இது மிகவும் அபூர்வமானது ஆனால் ஆண்டுக்கு சுமார் 600 பேர் இதற்குப் பலியாகின்றனர். வியப்பு என்னவென்றால் இது அமெரிக்காவின் 44 மாநிலங்களிலும் மருத்துவமனைகளில் காணப்படுகிறது.
இந்த ஆராய்ச்சியில் நாங்கள் தீர்வை நெருங்கிக் கொண்டிருக்கிறோம்" என்று டாக்டர் மைக்கேல் பெல் நம்பிக்கையுடன் கூறுகிறார்.
"எம்.ஆர்.எஸ்.ஏ. என்று அழைக்கப்பட்ட நோய்த் தடுப்பு மருந்துகளுக்குக் கட்டுப்படாத மற்றொரு வகை பாக்டீரியாவின் தாக்குதலும் இப்போது பாதியாகக் குறைந்துவிட்டது. அதே சமயம் மருத்துவமனை அல்லாத பிற இடங்களில் இந்த நோய்த் தொற்று இரட்டிப்பாகிவிட்டது. அது மருத்துவமனைகளில் உள்ள எண்ணிக்கையைவிட அதிகமாகிவிட்டது. மருந்துகளைக் கொடுத்து கட்டுப்படுத்த லாம் என்றால் அவை வேறு இடங்களுக்குச் சென்று பரவுவது குறிப்பிடத்தக்கது" என்கிறார் அயோவா பல்கலைக்கழக தொற்றுநோய்த் தடுப்புப் பிரிவு துறையைச் சேர்ந்த எலி பெரன்சிவிச் தெரிவிக்கிறார்.
"கால்நடைப் பண்ணைகளுக்கு அருகில் உள்ள வீடுகளில் வசிப்போரில் 38% பேருக்கு எம்.ஆர்.எஸ்.ஏ. வகை பாக்டீரியாக்களின் தொற்று ஏற்படுவதற்கான வாய்ப்பு ஏற்பட்டிருக்கிறது.
மிருதுவான தோல் அல்லது திசுக்கள் உள்ளவர்கள் இந்த பாக்டீரியாக்களால் தாக்கப்படுகின்றனர். இதற்குப் பண்ணைகளில் உள்ள நோய் எதிர்ப்புக் கிருமிகளைவிட வேறு காரணங்களும் இருக்கலாம்" என்று இந்த ஆய்வுகளில் ஈடுபடாத ஆனால் தகவல் தெரிந்த ஆய்வர்கள் தெரிவிக்கின்றனர்.
நோய்த்தடுப்பு மருந்து மாத்திரைகள் விற்பனை உலகம் முழுக்க கோடிக்கணக்கான ரூபாய்களில் நடக்கிறது. டாக்டர்கள் தங்களுடைய அனுபவம், படிப்பு ஆகியவற்றின் அடிப்படையில் மருந்து மாத்திரைகளைப் பரிந்துரைக்கின்றனர்.
ஆனால் அவற்றுக்கும் கட்டுப்படாமல் பாக்டீரியாக்கள் வலுப்பெற்று வருவதை இந்த ஆய்வுகள் சந்தேகமில்லாமல் நிரூபிக்கின்றன.
தி நியூயார்க் டைம்ஸ் தமிழில்: சாரி